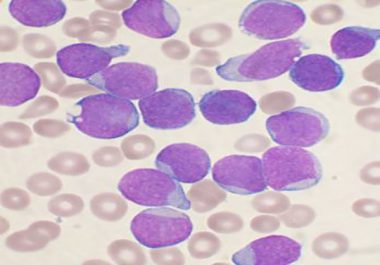

An Interview with Carl June, MD, a Pioneer in CAR T-cell Therapy
In 2012, Carl June, MD, a pioneer in the development of chimeric antigen receptor (CAR) T-cell therapy, helped treat Emily Whitehead, the...


In 2012, Carl June, MD, a pioneer in the development of chimeric antigen receptor (CAR) T-cell therapy, helped treat Emily Whitehead, the...
The first paper to be accepted by the AACR’s latest journal, Blood Cancer Discovery, was published online last week....